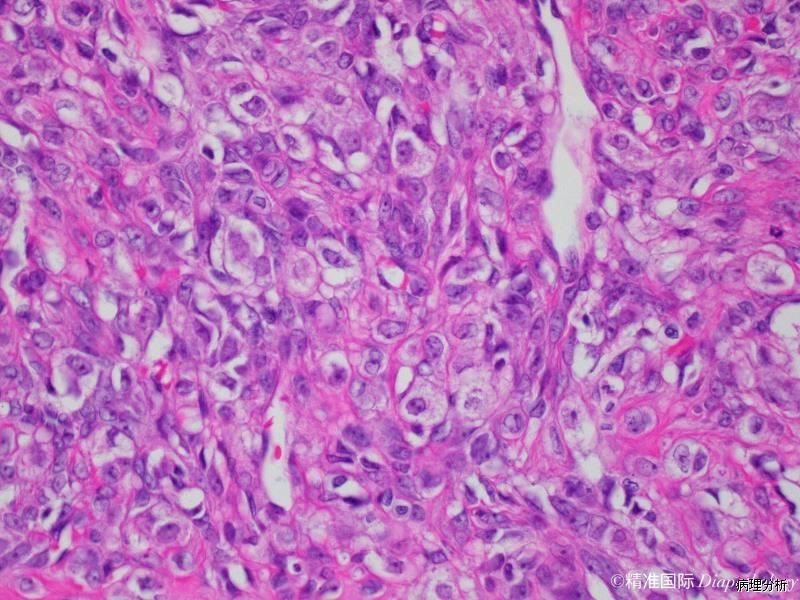

卵巢硬化性间质瘤
Sclerosing Stromal Tumor of the Ovary
概述:
良性肿瘤,表现为在细胞稀疏、水肿或胶原背景上圆形与梭形细胞密集混合增生形成结节。
发病部位: 卵巢
诊断要点:
常发生于年轻女性,平均发病年龄 27 岁,几乎全为单侧发病,临床表现主要与卵巢肿块有关,很少有激素活性;
典型者表现为单侧、孤立性、边界清晰的肿块,常为实性,切面黄色-白色,水肿常见,可伴囊腔形成,极少数标本呈单房囊性;
典型特征是致密的胶原化或水肿样少细胞区将细胞丰富区分隔成结节状,似分叶状;
结节内纤维母细胞和圆形、空泡样、印戒样细胞杂乱无章地分布;
有时可见含脂细胞,可能是失活的或轻度活化的黄体细胞,在罕见的有功能的硬化性间质瘤中,这种细胞更像黄素化卵泡膜细胞瘤中的细胞;
结节内可伴有硬化,有些结节内可见明显的薄壁血管;
个别硬化性间质瘤有明显的黏液样变,其中部分病例卵巢黏液瘤存在形态上的重叠。
鉴别诊断:
硬化性间质瘤与纤维瘤、卵泡膜细胞瘤和类固醇细胞瘤的比较
硬化性间质瘤 | 纤维瘤 | 卵泡膜细胞瘤 | 类固醇细胞瘤 | |
年龄 | 平均27岁 | 10%<30岁 | 平均年龄63岁 | 25%<30岁 |
功能 | 一般无功能 | 无功能 | 一般为雌激素性 | 一般为雄激素性 |
大体多彩状 | 有 | 无 | 无 | 无 |
假小叶结构 | 有 | 罕见 | 罕见 | 无 |
明显的扩张血管 | 有 | 罕见 | 罕见 | 罕见 |
两种细胞类型 | 有 | 无 | 仅见于黄素化型 | 无 |
大片透明变性 | 无 | 常见 | 常见 | 无 |
生物学行为 | 良性 | 几乎总是良性 | 几乎总是良性 | 有时恶性 |
← 卵巢纤维肉瘤 卵巢性索-间质肿瘤,非特指型 →